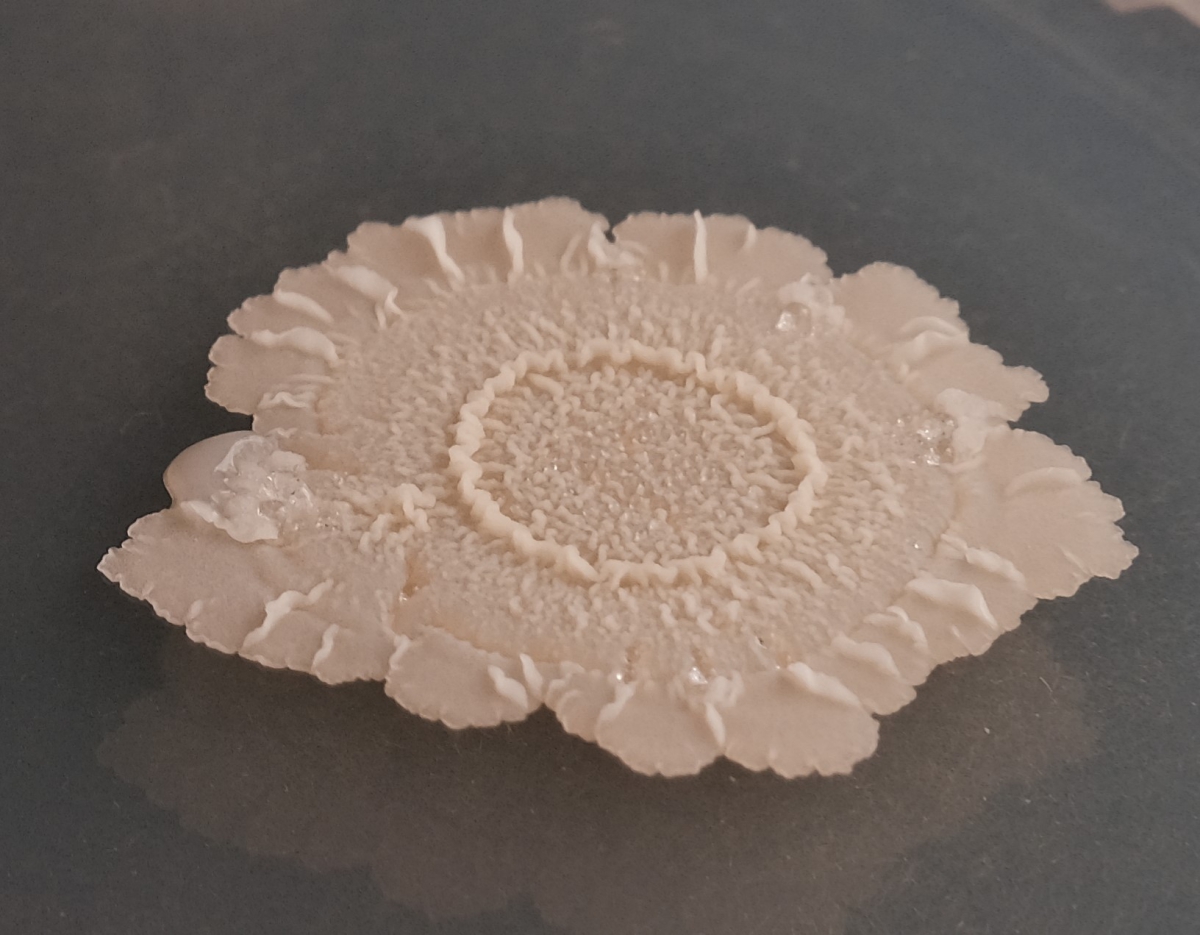

Hygienic, clean, healthy
The microbe of the year 2023 can even be purchased in pharmacies. Bacillus subtilis is considered to be health-promoting and is therefore sold as a probiotic. As a food ingredient, the microbe has long been known in Asia. In livestock farmiing, this bacterium is used as an alternative to antibiotics. Bacillus subtilis also produces vitamins and enzymes on an industrial scale, for example used in detergents. And it even heals cracks in concrete.
If you take a toilet break at a freeway service station, you benefit from the healthy effect of Bacillus subtilis. These harmless bacteria form permanent forms (spores) that can easily be added to the flush water, where they germinate quickly under good conditions and multiply rapidly. Thus they displace other, usually slower-growing microorganisms and ensure hygienic conditions.
Enzymes from Bacillus subtilis are used in laundry washing: Amylases, proteases, lipases from Bacillus strains break down the most important dirt, namely starch, proteins and fats - and do so at low temperatures, which saves energy during washing.

Replacing antibiotics?
The Microbe of the Year 2023 also plays a role in nutrition: Many people in Asia ferment soybeans with the help of Bacillus subtilis to produce traditional foods that are rich in minerals and vitamins and have a health-promoting effect, for example the Japanese Natto. Bacillus subtilis is also used as a probiotic - a microorganism providing health benefits. Sporulation contributes to this use: Spores from selected strains survive heat treatment (such as of animal feed) and the acidic environment in the stomach and small intestine. In the body, they inhibit pathogens, strengthen the intestinal barrier and the immune system.
Bacillus subtilis can also reduce the use of antibiotics in livestock farming: A Bacillus-based probiotic prevents an intestinal infection common in poultry farming. The bacteria also strengthen plant growth, protect them from pathogens and help absorb nutrients from the soil.
In addition, Bacillus subtilis forms complex and robust biofilms - assemblies of cells, sugars and proteins that allow them to attach to surfaces. An interesting use of Bacillus subtilis biofilms is their potential application in Alzheimer's disease: In animal models, the biofilms protect nerve cells.

Healing cracks in concrete
Bacillus subtilis also helps in the construction industry. In the aging process of concrete, small cracks appear; microbes can close these cracks: they form carbonate (CO32-) ions in the concrete - a real feat in this highly alkaline, oxygen-poor and hot environment (temperatures of 60°C arise during curing). Spores of Bacillus subtilis are used for self-healing of concrete: Water penetrating through cracks causes the spores to grow out, which then form carbonate, closing the cracks.
Since Bacillus subtilis is robust and grows quickly, it efficiently converts organic substrates into biotechnological products. Therefore, it is used for numerous production processes. For example, Bacillus subtilis produces vitamin B2 (riboflavin), as well as pantothenic acid (vitamin B5) and g-polyglutamic acid - as thickener, humectant or cyroprotectant in the food and cosmetics industries.
The genome of Bacillus subtilis is very well documented. It has been artificially reduced to a MiniBacillus to understand what minimum components are required for cellular life. This is also helpful for biotechnological applications to produce microbial target substances without by-products. Already, Bacillus subtilis is indispensable in many industries, and many more innovations are expected.
further information:
- photos/press images (respect copyrights)
- working groups, literature, video
- press release Microbe of the Year 2023
- Poster 2023
- presentation for lecturers 2023 (German)

